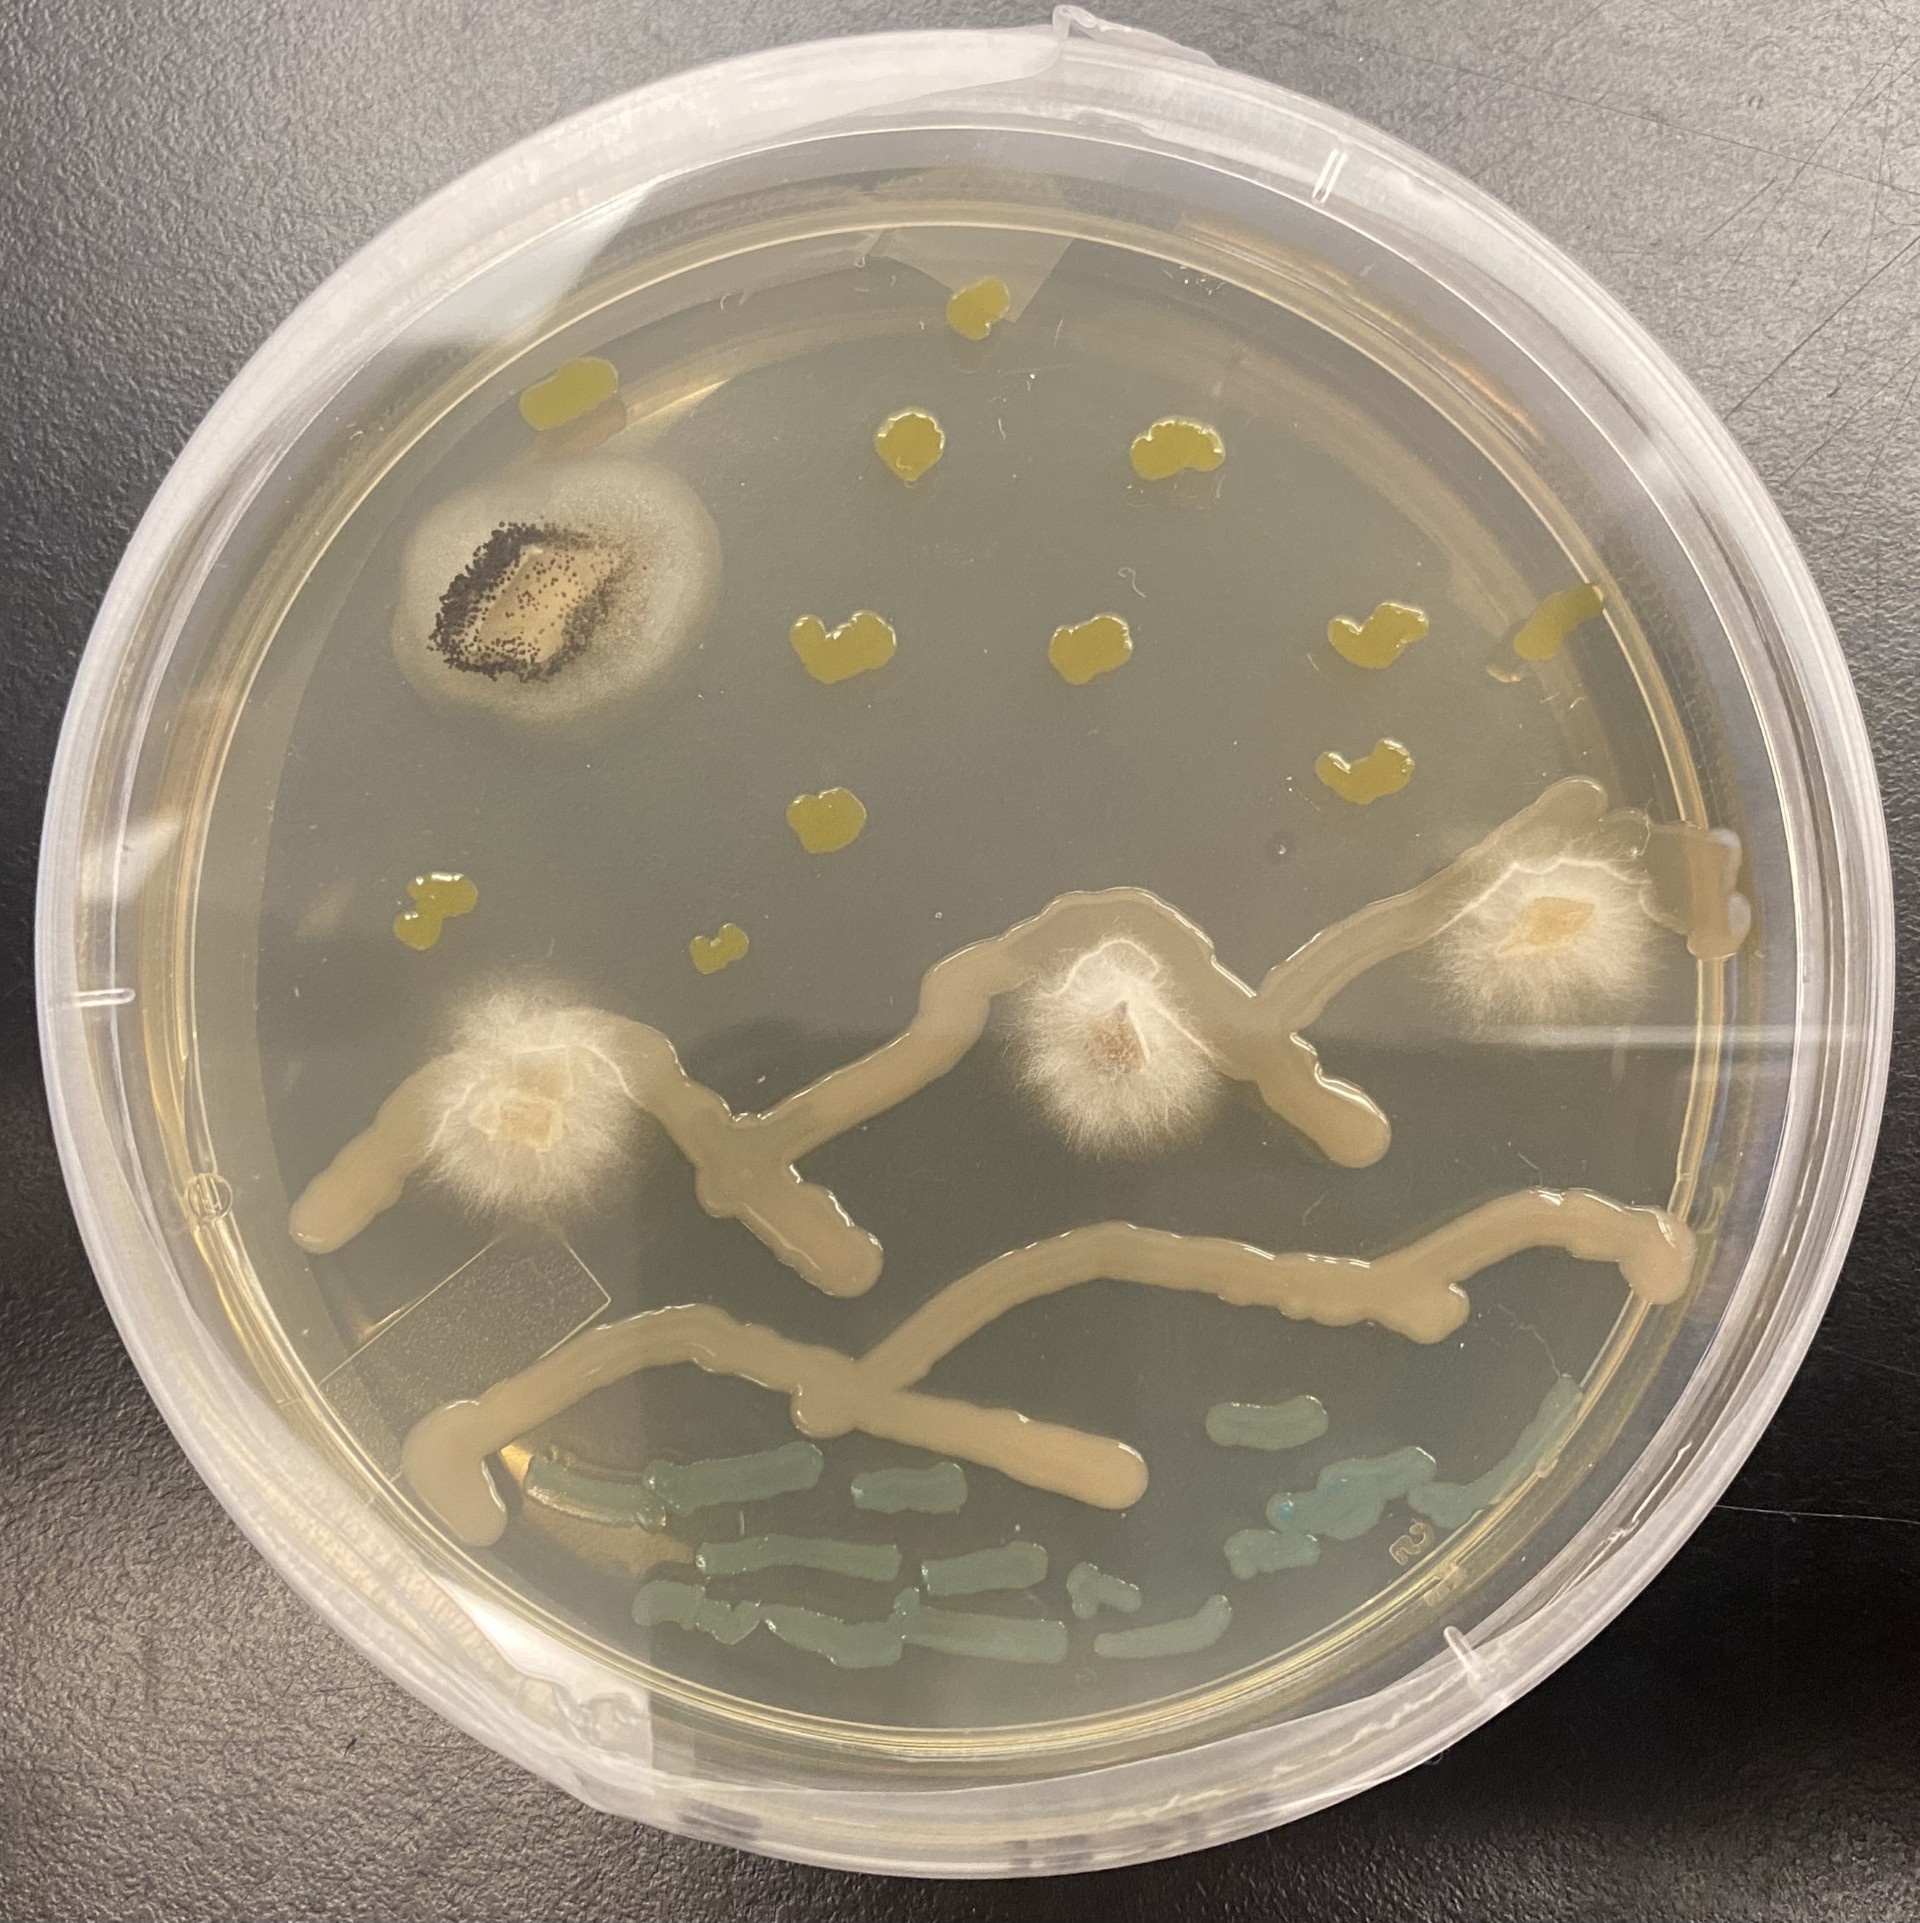
Mixing Science With Art: Biology of Microbes at CC

-
Ramirez ’17 Enjoys a Science-Focused Life on the Adult Block Plan
A lover of languages, arts, and sciences, Sophie Ramirez ’17 was drawn to CC from the beginning. “I was looking for a new challenge. I was looking for something completely out of left field. And that was exactly what CC offered.” Then, she encountered all the opportunities and resources, such as the Writing Center, the… Read More
-
Leading in Science with Accountability: National Academy of Sciences President Marcia McNutt ’74
“I’m the kind of person that likes to focus on something and get it solved,” admits Marcia McNutt ’74, President of the National Academy of Sciences. She’s tackled big challenges throughout her career, from plate tectonics to oil blowouts to sexual harassment in science. And it all began with her first block at CC in… Read More
-
Mixing Science With Art: Biology of Microbes at CC
CC students create art using biology in this multi-week agar art lab project in Dr. Jesús Peña’s Biology of Microbes class. Agar art is created by culturing microorganisms like bacteria or yeast in specific patterns to create images. When grow on agar in a petri dish, microbes grow as discrete colonies, and each colony will… Read More
-
Organismal Biology & Ecology Alum Uses Liberal Arts Education to Increase Plant Awareness
CC is known for its strong liberal arts education, where students are taught to think critically, express themselves articulately, and share ideas in a way that others can understand. These lessons, combined with CC’s strong science programs, has set Josh Felton ’22 up for a successful career in botany, the scientific study of plants. “CC… Read More
-
Sherman ’21 Works to Combine Indigenous Knowledge with Western Science
As a proud member of the Navajo Nation, Carissa Sherman ’21 is using her Diné heritage and passion for helping people to combine Indigenous knowledge with Western science. While some may think that the best way to pursue a career in a STEM field is to attend a research-focused large university, Sherman, a former Molecular… Read More
-
Poli Sci Alum Manages Local House District Campaign
Tom Byron ’23 took the lessons he learned as a Political Science major at CC to get his dream campaign job as the Campaign Manager for House District 18 candidate Amy Paschal. “I wouldn’t be doing this job if it wasn’t for CC,” says Byron. “The Political Science Department supported my campaign work from the… Read More
-
CC Campus Safety Officer Serves as Delegate to the DNC
Joe Shelton has been a member of CC’s Campus Safety team for six years, currently serving as Midnight Shift Officer. In his daytime hours, he serves his community in another way, as an Executive Council Member for the El Paso County Democratic Party. And in August, Shelton was one of Colorado’s delegates to the Democratic… Read More
-
CC Grad Turns On-Campus Organizing into Post-Graduate Job
In just a few months, Maggie Mixer ’24 went from on-campus organizing to managing an entire campaign. When asked how, Mixer has three words: The Block Plan. “Campaign work is both a marathon and a sprint, so the Block Plan’s training to manage large volumes of work efficiently in short periods of time is very… Read More
-
Timing is Key for Political Science Alum Working for Colorado Attorney General
From taking a block off to work on a local campaign as a sophomore, to now working as a constituent services assistant for Colorado Attorney General Phil Weiser, Teddy Weiss ’21 has learned the importance of taking advantage of every opportunity he comes across and staying committed to his goals. Weiss, a former Political Science… Read More